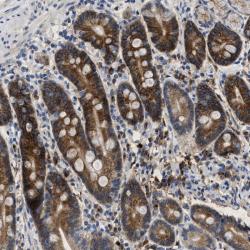

sc-20816
antibody from Santa Cruz Biotechnology
Targeting: KCNQ1
JLNS1, KCNA8, KCNA9, Kv7.1, KVLQT1, LQT, LQT1
Antibody data
- Antibody Data
- Antigen structure
- References [4]
- Comments [0]
- Validations
- Immunohistochemistry [1]
Submit
Validation data
Reference
Comment
Report error
- Product number
- sc-20816 - Provider product page

- Provider
- Santa Cruz Biotechnology
- Proper citation
- Santa Cruz Biotechnology Cat#sc-20816, RRID:AB_2131551
- Product name
- Anti-KCNQ1
- Antibody type
- Polyclonal
- Antigen
- Recombinant full-length protein
- Reactivity
- Human
- Host
- Rabbit
Submitted references Effect of Fe(3)O(4)-magnetic nanoparticles on acute exercise enhanced KCNQ(1) expression in mouse cardiac muscle.
Directed differentiation of mouse cochlear neural progenitors in vitro.
In situ measurement of airway surface liquid [K+] using a ratioable K+-sensitive fluorescent dye.
Deafness in LIMP2-deficient mice due to early loss of the potassium channel KCNQ1/KCNE1 in marginal cells of the stria vascularis.
Liu L, Chen B, Teng F, Shi L, Jing N, Wang L, Chen N, Xia G, Li X
International journal of nanomedicine 2010 Mar 9;5:109-16
International journal of nanomedicine 2010 Mar 9;5:109-16
Directed differentiation of mouse cochlear neural progenitors in vitro.
Lin J, Feng L, Hamajima Y, Komori M, Burns TC, Fukudome S, Anderson J, Wang D, Verfaillie CM, Low WC
American journal of physiology. Cell physiology 2009 Mar;296(3):C441-52
American journal of physiology. Cell physiology 2009 Mar;296(3):C441-52
In situ measurement of airway surface liquid [K+] using a ratioable K+-sensitive fluorescent dye.
Namkung W, Song Y, Mills AD, Padmawar P, Finkbeiner WE, Verkman AS
The Journal of biological chemistry 2009 Jun 5;284(23):15916-26
The Journal of biological chemistry 2009 Jun 5;284(23):15916-26
Deafness in LIMP2-deficient mice due to early loss of the potassium channel KCNQ1/KCNE1 in marginal cells of the stria vascularis.
Knipper M, Claussen C, Rüttiger L, Zimmermann U, Lüllmann-Rauch R, Eskelinen EL, Schröder J, Schwake M, Saftig P
The Journal of physiology 2006 Oct 1;576(Pt 1):73-86
The Journal of physiology 2006 Oct 1;576(Pt 1):73-86
No comments: Submit comment
Supportive validation
- Submitted by
- per
- Main image
- Experimental details
- Immunohistochemical staining of human duodenum shows strong cytoplasmic and membranous positivity in glandular cells.
- Validation comment
- Staining pattern partly consistent with experimental and/or bioinformatic data.